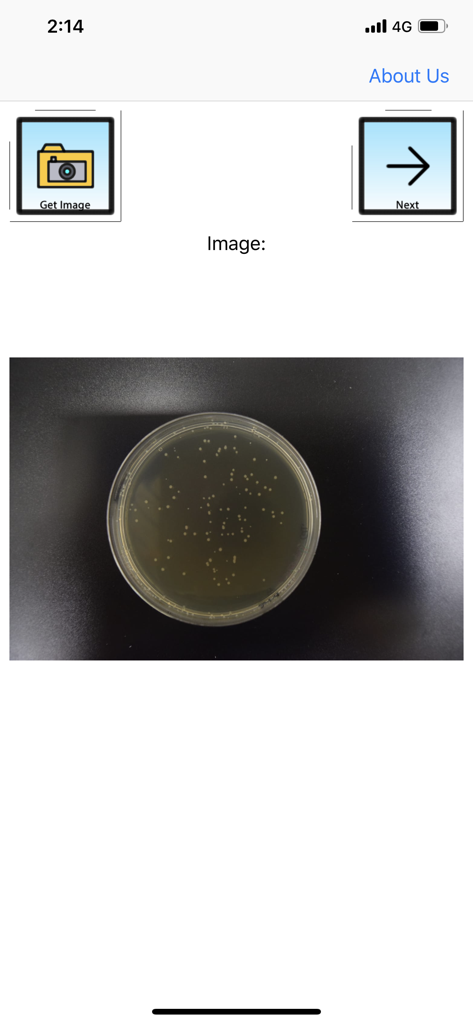
APD Colony Counter App Lite - APD Colony Counter App Lite Benutzeroberfläche, die eine Agarplatte mit Bakterienkolonien zur Analyse anzeigt
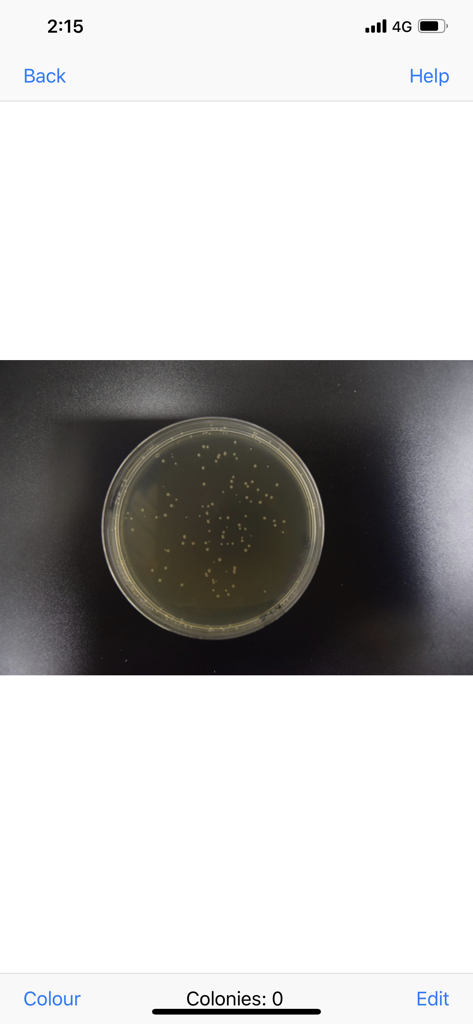
APD Colony Counter App Lite - APD Colony Counter App Benutzeroberfläche, die eine Petrischale mit Bakterienkolonien zur Analyse anzeigt
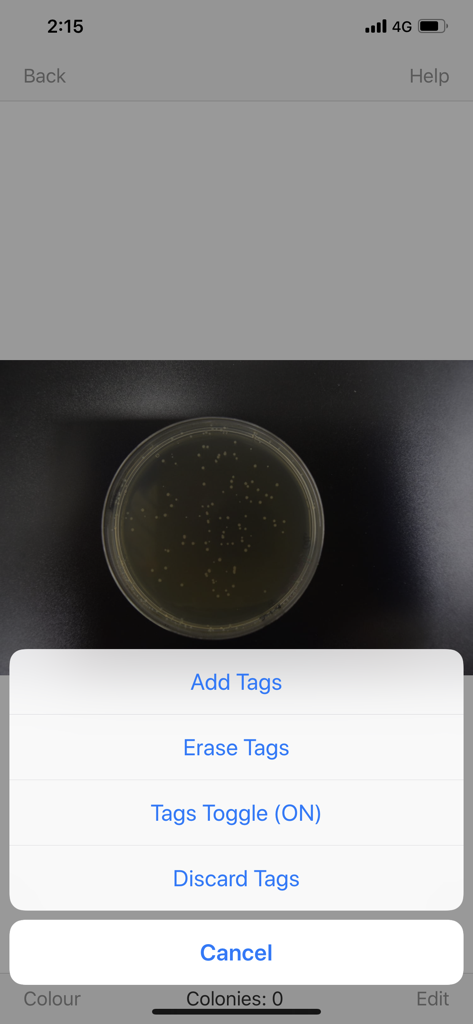
APD Colony Counter App Lite - Oberfläche der APD Colony Counter Lite App, die ein Menü mit Optionen zum Hinzufügen oder Löschen von Markierungen auf einem Agarplattenbild anzeigt
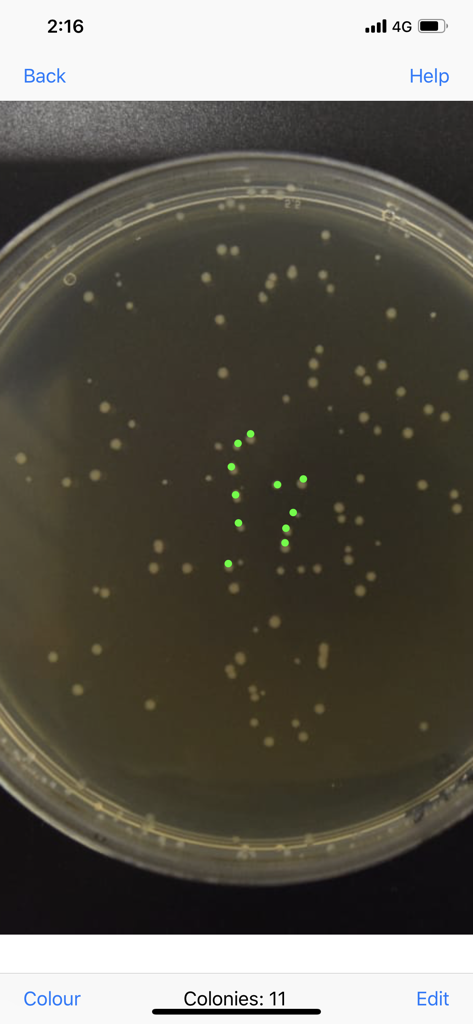
APD Colony Counter App Lite - Manuelles Zählen von Bakterienkolonien auf einer Agarplatte in der APD Colony Counter App

Diese Seite ist keine offizielle Seite der App oder ihres Entwicklers, sondern eine unabhängige redaktionelle Veröffentlichung, die zu Informations- und Kommentarzwecken erstellt wurde. Sofern nicht ausdrücklich anders angegeben, sind weder die App noch ihr Entwickler mit MWM, Apple, Google Play, dem App-Herausgeber oder dem Entwickler der App verbunden, von ihnen unterstützt, gesponsert, autorisiert oder anderweitig offiziell verbunden, und nichts auf dieser Seite impliziert, dass die App unter Verwendung der Dienste von MWM entwickelt wurde. Alle Marken, Logos, Screenshots und andere Inhalte bleiben Eigentum ihrer jeweiligen Inhaber.
Downloads
0Bewertung
Bewertungen gesamt
0Herausgeber
Kategorie
ProductivitySprachen
1Neueste Version
1.0Größe
8.5 MBErstveröffentlichung
19. Okt. 2018Präzise Zählung für moderne Labore
Verwandeln Sie Ihr Smartphone in ein professionelles Kolonienzählgerät. Unsere von Wissenschaftlern für Forscher entwickelte App optimiert die Datenerfassung, um die Genauigkeit Ihrer Veröffentlichungen zu verbessern.
Publikationsreife Ergebnisse
Erstellen Sie kommentierte Screenshots, die in Nature Methods zitiert werden, und machen Sie es einfach, verifizierte visuelle Beweise in Ihre nächste Zeitschrifteneinreichung oder Ihren Laborbericht aufzunehmen.
Eliminieren Sie subjektive Fehler
Ersetzen Sie manuelle Zählungen durch digitale Präzision. Verwenden Sie anpassbare Markierungen und die Touch-to-Count-Funktion, um sicherzustellen, dass jede Kolonie korrekt erfasst wird.
Ähnliche Apps
Top-gerankte Apps in derselben Kategorie

ChatGPT
OpenAI OpCo, LLC

Google Gemini
Google LLC

Claude by Anthropic
Anthropic PBC

Gmail - Email by Google
Google LLC

千问 - 阿里最强大模型官方AI助手
Shanghai Zhixin Puhui Technology Co., Ltd.

Grok
X.AI Corporation

Google Drive
Google LLC

Microsoft Authenticator
Microsoft Corporation

Google Sheets
Google LLC
Diese Seite ist keine offizielle Seite der App oder ihres Entwicklers, sondern eine unabhängige redaktionelle Veröffentlichung, die zu Informations- und Kommentarzwecken erstellt wurde. Sofern nicht ausdrücklich anders angegeben, sind weder die App noch ihr Entwickler mit MWM, Apple, Google Play, dem App-Herausgeber oder dem Entwickler der App verbunden, von ihnen unterstützt, gesponsert, autorisiert oder anderweitig offiziell verbunden, und nichts auf dieser Seite impliziert, dass die App unter Verwendung der Dienste von MWM entwickelt wurde. Alle Marken, Logos, Screenshots und andere Inhalte bleiben Eigentum ihrer jeweiligen Inhaber.